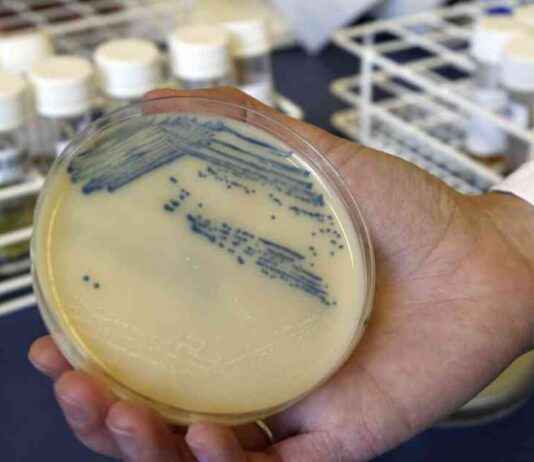
Warning: Drug-Resistant Germs Could Cause Millions of Deaths in Future Decades news-18092024-190105

Trump Rally in Coachella Valley: California Visit and Event Details
Former President Trump is set to hold a rally in the Coachella Valley in California, just weeks before the election. The event will take...
Jay Johnston Sentenced to Prison for Involvement in Jan. 6 Incident
Jay Johnston, a well-known actor from television comedies such as “Bob’s Burgers” and “Arrested Development,” has been sentenced to one year in prison for...
Afghanistan Makes History with First ODI Win Against South Africa
Afghanistan Creates History with First ODI Victory Against South Africa In a historic moment for Afghan cricket, the national team secured their first-ever One Day...
Pelosi undergoes hip replacement surgery at U.S. military hospital in Germany
House Speaker Nancy Pelosi, a prominent figure in American politics, recently underwent hip replacement surgery at a U.S. military hospital in Germany. The surgery...
Conflict Escalates: Israel Strikes Beirut Suburb Amid Tensions with Hezbollah –...
Israel's recent strike on a Beirut suburb amidst escalating tensions with Hezbollah has left at least 14 people dead and 66 others wounded, according...
Trump Campaign Staff Involved in Altercation at Arlington National Cemetery
Two members of Donald Trump’s campaign staff were involved in a verbal and physical altercation with an official at Arlington National Cemetery on Monday....
EU Leaders Warn Trump: China Could Benefit from Transatlantic Trade War
EU Leaders on High Alert: Impending Transatlantic Trade War Threatens Global Stability In a world where economic alliances can shift as quickly as the wind,...
Gov. Walz’s Background Preparation for White House Campaign
Minnesota Governor Tim Walz recently shared insights into how his background has prepared him for a potential White House campaign. During a campaign rally...
Compounded Weight Loss Drugs: A Trend Among Doctors
Compounded Weight Loss Drugs: A Growing Trend Among Doctors Health care providers are increasingly turning to compounded versions of popular weight loss drugs like Wegovy...
Supreme Court Blocks Biden Admin Rules on Sex Discrimination in Schools
The U.S. Supreme Court made a significant decision on Friday regarding the Biden administration's new rules on sex discrimination in schools that receive federal...
Tianjin City Embraces DeepSeek in Domestic AI Push
In a groundbreaking move, the northern port city of Tianjin in China has recently embraced the cutting-edge Chinese artificial intelligence system known as DeepSeek....
Winners and Losers in China’s Markets: DeepSeek and Trump Tariffs
Investors who returned to mainland China's markets after the Lunar New Year holiday were met with a whirlwind of developments. From the meteoric rise...
Chinese Leader Considering Trump’s Invitation for US Visit
US President Donald Trump recently expressed his anticipation for a potential visit from Chinese President Xi Jinping to Washington, highlighting their strong relationship amidst...
99-Year-Old Woman Moves After 60 Years in New Jersey
At the age of 99, June Scott made a life-changing decision to move out of her home in New Jersey after residing there for...
Challenges Facing Donald Trump in Orange County Politics
Orange County, a historically conservative stronghold, has seen a shift towards a more politically and demographically diverse region over the past decade. Despite this...
Recap of Top Photos from Week 1 of 2024 Paris Olympics
The 2024 Paris Olympics kicked off with a bang, showcasing incredible moments of triumph and defeat as athletes from around the world battled it...
Donald Trump Chooses Matt Gaetz as Anti-Attorney General
President-elect Donald Trump's choice of Florida Rep. Matt Gaetz as attorney general has raised serious concerns about the future of the Department of Justice....
Why Young Chinese Delay Retirement Planning: Insights and Solutions
For many young people in China, the government’s call to prepare for retirement decades in advance feels out of touch with reality. With rising...
SEO Title: Debunking Fake News: Kamala Harris NOT Involved in Hit-and-Run...
Russian Surrogates Spread Disinformation About Kamala Harris In recent news, it has come to light that a fictitious San Francisco news outlet, allegedly linked to...
Arizona Prosecutor’s Mistake Halts Trump’s Potential Fifth Criminal Indictment
**Arizona Prosecutor's Mistake Halts Trump's Potential Fifth Criminal Indictment** The recent developments in the Arizona false electors case have shed light on the legal jeopardy...
Ethel Kennedy, Widow of Robert Kennedy, Passes Away: A Life Lived...
Ethel Kennedy, the widow of Sen. Robert F. Kennedy, recently passed away at the age of 96. She was known for her stoic presence...
Gaza Evacuations: Urgency and Displacement in Crisis
Since October of last year, the situation in Gaza has been dire, with 90 percent of the population forced to evacuate from their homes....
California Prepares for Increase in Heat-Related Deaths as National Temperatures Rise
California Braces for Surge in Heat-Related Deaths as National Temperatures Soar As temperatures continue to rise across the United States, a new study published in...
Biden’s Approval of Ukraine’s Use of Long-Range Missiles: Impact on U.S.-Russia...
President Biden has made a significant change in U.S. policy towards Ukraine, allowing them to use long-range missiles to target deeper inside Russia. This...
Christian Villages Caught in the Crossfire of Israel-Hezbollah Conflict
Despite the predominantly Christian village of Ain Ebel being mostly out of the crossfire between Israel and Hezbollah for much of the last year,...
China’s Perspective on the Bangladesh Uprising: Analysis and Implications
China's Perspective on the Bangladesh Uprising: Analysis and Implications Recently, there has been a lot of talk about the uprising in Bangladesh and the role...
Women Make Better Doctors: Exploring Gender Disparities in Medicine
Female doctors face unique challenges in the medical field, as highlighted in a recent local newspaper article that explores gender disparities in medicine. Despite...
China’s Energy Security Update: Scientist’s Death in SCMP Highlights
China's Energy Security: A Closer Look at the Latest Developments Recently, the South China Morning Post (SCMP) shed light on some of the most significant...
Cash Shortage in Gaza: Paper Money Disintegration Adds to Desperation
Cash Shortage in Gaza: Paper Money Disintegration Adds to Desperation DEIR AL BALAH, Gaza Strip— In the heart of Gaza, Mohammad Al-Ashaqar, a seasoned jeweler,...
No More Debates: Trump’s Decision After First Harris Face-Off
Former US President Donald Trump has made a decision to not engage in any more debates with Vice President Kamala Harris after their recent...
Trump Confirms Talks with Xi Since Inauguration
US President Donald Trump has recently disclosed that he has been in communication with Chinese President Xi Jinping since taking office, highlighting ongoing diplomatic...
Former Police Chief to Face Charges in Kansas Newspaper Raid Scandal
Special prosecutors in Kansas have announced their intention to charge a former police chief with obstruction of justice in connection with a raid on...
Tragedy Strikes as Eight People Perish Trying to Cross English Channel
Tragedy Strikes as Eight People Perish Trying to Cross English Channel In a heartbreaking turn of events, tragedy struck once again as at least eight...
Nicaragua Cracks Down on Civil Society: 1,500 NGOs Banned
Nicaragua's Crackdown on Civil Society: 1,500 NGOs Banned Nicaragua’s government, led by President Daniel Ortega, has recently taken a drastic step in its ongoing crackdown...
Mexico’s Stance on Accepting Military Deportee Flights: President Sheinbaum’s Response
Mexican President Claudia Sheinbaum Was Mum on the Acceptance of Military Deportee Flights Mexican President Claudia Sheinbaum found herself in a precarious position on Tuesday...
The True Cost of Bukele’s Clean Up of El Salvador
SAN SALVADOR — The last time I was in El Salvador, nearly a decade ago, the capital was gripped by the violence of gangs...
China’s Export Growth Slows Due to US Tariffs
China's Export Growth Slows Amid US Tariffs China's export growth has hit a speed bump in the early months of 2025, marking a notable slowdown...
Women Athletes Propel Team USA to Over Half of Olympic Medals
American women athletes have truly shined in the recent summer Olympics, bringing home over half of the medals for Team USA. Out of the...
Top 10 Players to Watch at ICC Women’s T20 World Cup...
Top 10 Players to Watch at ICC Women’s T20 World Cup 2024 The ICC Women’s T20 World Cup 2024 promises to be a thrilling showcase...
Evolution of Kamala Harris’ Stances: 5 Key Times of Change
Vice President Kamala Harris has faced criticism for the evolution of her stances on key issues, including fracking, border security, healthcare, defunding the police,...
China’s Trade Talk Comments Increase Pressure on US
China’s confirmation that it is evaluating whether to reopen talks with the United States over a potential deal to de-escalate the trade war should...
Trump’s Counter Programming Steals DNC Spotlight from Harris
Former President Donald Trump is making a splash this week with a series of events planned to counter the Democratic National Convention in Chicago....
The Rise of Urban Rats in Cities Due to Climate Change
Rats, those pesky rodents that scurry through city streets and alleyways, are thriving in urban environments due to the effects of climate change. The...
Deregulatory Wish List Sent to Trump by Industrial & Business Groups
More than a hundred industrial trade groups and chambers of commerce have united in a bold move, sending a 21-page wish list to President-elect...
Banning Transgender Athletes in Sports: Trump’s Stance on San Jose State...
Donald Trump recently voiced his opinions on the controversy surrounding transgender athletes in women's volleyball, specifically in the Mountain West Conference. During a town...
Haiti Gang Violence Claims Over 3,600 Lives in 2021: UN Data
Haiti has been plagued by a surge in gang violence, with over 3,600 lives lost in the first half of 2021 alone, according to...
Iraqi Yazidis Still Fear Replaying ISIS Genocide: A Decade Later
Iraqi Yazidis Still Face Lingering Trauma and Fear a Decade After ISIS Genocide As the world marks the 10th anniversary of the brutal ISIS genocide...
Trump’s Former Aides Warn: Second Term Would Make Him More Dangerous
Former White House chief of staff, retired Marine Gen. John F. Kelly, recently spoke out against his former boss, Donald Trump, labeling him as...
Algeria Court Certifies President Tebboune’s Landslide Re-Election Victory
Algeria Court Certifies President Tebboune's Landslide Re-Election Victory Algerian President Abdelmadjid Tebboune has secured a second term in office with an overwhelming 84.3 percent of...
Democrats Express Concern Over Potential Hunter Biden Pardon
Democrats Express Concern Over Potential Hunter Biden Pardon President Biden’s decision to pardon his son Hunter has caused a stir in the political landscape, with...
Documentary Professionals Converge at Sarajevo Industry Days
Documentary Professionals Gather at Sarajevo Industry Days Sarajevo Industry Days, an event dedicated to showcasing the power and art of storytelling in the world of...
Israeli Jets Trigger Sonic Booms in Beirut; Nasrallah Threatens Retaliation
Israeli fighter jets flew low over Beirut, causing sonic booms that shook windows across the Lebanese capital. This display of military power came in...
Cutting Christmas Trees on Public Lands: Forest Service Encourages with Permits
Forest Service Encourages Cutting Christmas Trees with Permits Amidst the hustle and bustle of the holiday season, many families are embarking on a unique tradition...
Putin’s Lowered Nuclear Strike Bar Amid Ukraine Attacks: Impact Analysis
Russian President Vladimir Putin sent shockwaves through the international community on Wednesday when he announced a significant shift in Moscow's nuclear policy. In a...
Wang Yi’s Free Trade Message at UK-China Strategic Dialogue
In a rare visit to the United Kingdom after a decade-long absence, Chinese Foreign Minister Wang Yi emphasized his country's commitment to free trade...
Israel Recovers Bodies of Six Captives in Gaza
Israel Recovers Bodies of Six Captives in Gaza Israel's military has made a grim announcement, revealing that its troops have successfully recovered the bodies of...
Chinese Hiker Earns $41,000 Guiding Tourists Up Mountain
A young man from China, aged 26, managed to pocket a substantial sum of over 300,000 yuan (equivalent to US$41,000) in earnings last year...
Ne Zha 2 and DeepSeek: Inspiring Brighter Future in China
At the dawn of 2025, amidst the backdrop of escalating tensions between the United States and China, many harbored doubts about the future trajectory...
Israel’s Strategy Before Trump’s Presidency: Escalating Gaza and Hezbollah Conflicts
Israel's Strategy Before Trump's Presidency: Escalating Gaza and Hezbollah Conflicts President-elect Donald Trump has been actively engaging with Israeli Prime Minister Benjamin Netanyahu since the...
Columbia University President Minouche Shafik Resigns Amid Turmoil: Here’s What Happened
Columbia University President Minouche Shafik has announced her resignation amidst a period of turmoil at the prestigious Ivy League institution. Shafik, who took on...
Unlocking US Investment in Iran: Opportunities for Gulf States
As talks between Iran and the United States reach a pivotal moment, the prospect of Washington’s investment in Iran if sanctions are lifted looms....
Chinese Scientists Develop Missile Technology from Boeing’s Starliner Crisis
Chinese Scientists Revolutionize Rocket Technology from Boeing's Starliner Crisis In a fascinating turn of events, Chinese researchers have leveraged a long-standing NASA dilemma – the...
Cocaine Bricks Washing Up on Florida Beaches: Causes and Solutions
A package containing 16 bricks of suspected cocaine was discovered by guests on a beach in the Florida Keys, according to authorities. The Monroe...
Bears Rookie Diaries: Week 2 with Tory Taylor and Austin Booker
Bears rookie diaries with Tory Taylor, Austin Booker | Week 2 As reported by Gabby Hajduk Bears fourth-round pick Tory Taylor and fifth-round pick Austin Booker...
Israel Strikes Hezbollah Headquarters in Beirut, Causing Massive Explosions
At least 900 words long.
‘Gaza Protests Persist Despite DNC: Analysis and Updates’
Amidst the buzz of the Democratic National Convention (DNC) in Chicago, the city has seen a persistent wave of protests advocating for Palestinian rights....
Train Like Team USA Athletes: Q&A for Maximizing Your Workouts
The recent Olympic competition in Paris showcased incredible stories of athleticism, determination, and resilience. Whether you are looking to improve your fitness for a...
Supreme Court Denies Appeal for Green Party to be Included on...
Supreme Court Denies Appeal for Green Party to be Included on Nevada Presidential Ballot In a significant blow to the Nevada Green Party, the Supreme...
New Title: US Approves Innovative Chinese Painkiller to Combat Fentanyl Overdoses
The US Food and Drug Administration (FDA) has approved the first China-invented painkiller designed as a non-opioid alternative, giving it the potential to curb...
DirecTV and Disney Reach Deal to End ESPN, ABC Blackout
After a 13-day blackout, Walt Disney Co. and DirecTV have finally reached a resolution to their contract dispute, bringing relief to over 10 million...
JD Vance Interview: Debunking Trump’s Tariffs as a Tax on Americans
JD Vance Interview: Analyzing the Impact of Trump's Tariffs on Americans In a recent interview with JD Vance, the discussion delved into various topics ranging...
Quantum Cryptography System by Chinese Firm: Unhackable Solution
China Telecom Quantum Group recently unveiled what they are calling the world's first commercial cryptography system that can't be hacked, not even by those...
Navigating Economic Anxiety in Nevada: Understanding Voter Sentiments
Madonna Raffini, a retiree from Nevada, recently shared her experience while shopping for groceries for herself and her 96-year-old mother. She expressed her shock...
FDA Regulations on Secret Ingredients in Food: What You Need to...
FDA Regulations on Secret Ingredients in Food: What You Need to Know It’s a rule by the U.S. Food and Drug Administration that most Americans...
Challenges in Police-Prosecutor Relationship Highlighted by Two Deaths in Massachusetts Town
**Challenges in Police-Prosecutor Relationship Highlighted by Two Deaths in Massachusetts Town** Weeks after a mistrial was declared in the high-profile murder case of Karen Read,...
Strategies for Mexico to Counter Trump’s Threats: Expert Opinions
President-elect Donald Trump's intentions to implement his "America First" foreign policy approach have raised concerns about how Mexico will be impacted by his proposed...
Not All Christian Voters Are Conservative White Evangelicals: Pro-Kamala Group Sheds...
A group of Vice President Kamala Harris supporters is aiming to unite Christian voters who are moderate and progressive. The group, called Christians for...
Donald Trump’s Troublesome Convention Week: A Recap
Title: Donald Trump's Troublesome Convention Week: A Detailed Recap Donald Trump, the controversial figure in American politics, faced a troublesome week during the Democratic National...
China Urged to Consider 4% GDP Target and Job Support for...
China's Growth Target Under Scrutiny: A Call for Lowered Expectations As China gears up for the next five years, a former senior economic planner is...
FAA Refers 43 Abusive Plane Passengers to FBI as Incidents Decline:...
The summer of 2024 saw a surge in air travel, with a record-breaking number of passengers passing through airport security checkpoints. While most travelers...
Fujian Aircraft Carrier: China’s Catapult Technology in Action
CCTV included the footage of the electromagnetic catapult system in a report last week, with a view from an unidentified aircraft hurtling along the...
Revolutionizing Transportation: The Chinese Flying Car Phenomenon
China's rapid development in the realm of transportation has taken a futuristic turn with the emergence of flying cars, also known as electric vertical...
President Biden Pardons Son Hunter Biden, Citing Unfair Prosecution
President Biden Pardons Son Hunter Biden President Biden has issued a surprising and controversial "full and unconditional" pardon to his son, Hunter Biden. The decision...
Impact of India-Pakistan Rivalry on Russia-China led SCO Alliance
When Pakistan hosts the Shanghai Cooperation Organisation (SCO) summit next month, the presence or absence of Indian Prime Minister Narendra Modi will be a...
Democrats’ Efforts to Reclaim Patriotism from Republicans: A Column Analysis
As we navigate the complex landscape of patriotism in today's political climate, it is crucial to examine the shifting dynamics within the two major...
USA Women Make History with First-Ever Foil Gold at Paris 2024...
The United States women have made history at the Paris 2024 Olympics by winning the first-ever gold medal in the team foil fencing competition....
Plane Crash in Sao Paulo State: 62 People Aboard – News...
An airplane carrying 62 people crashed in a fiery accident in a residential area of a city in Brazil's Sao Paulo state, according to...
What Happens Next After Biden’s Narrow Victory in This Red California...
In 2020, Joe Biden won in Inyo County, a rural area in California, by a narrow margin of 14 votes. This was a significant...
China Urges Sports Fans to Behave at Olympics
Beijing is taking action against unruly sports fans who are negatively impacting the performance of Chinese athletes at the Paris Olympics. This crackdown is...
Israel Ends Limited Retaliation Bombardment on Iran: Update
Israel's retaliatory bombardment of Iran on Saturday was limited in scope, but Western nations, including the U.S., warned that further escalation could lead to...
Chaos and Confusion Unfold After Trump Assassination Attempt – Latest Video...
The newly released body camera footage from the Butler Township Police Department reveals the chaotic law enforcement response to the assassination attempt on former...
Anderson Cooper’s Close Call: Reporting Live as Hurricane Milton Sends Debris...
Anderson Cooper had a scary moment during a live broadcast while reporting on Hurricane Milton in Florida. The CNN anchor was on the shore...
China’s Efforts to Retain Top Tech Talent Amid US Rivalry
In the fast-paced world of tech innovation, one of the latest headlines grabbing attention is the rapid ascent of Chinese AI development company DeepSeek....
Mexico’s President Defends Immigrants Against Trump’s Deportation Plans
Mexico's President, Claudia Sheinbaum, has spoken out against President-elect Donald Trump's plans for mass deportations of immigrants, particularly Mexican nationals. She emphasized that immigrants...
Manila’s Transparency Initiative Counters Beijing’s South China Sea Actions
In the vast expanse of the South China Sea, a battle of wills rages on between the Philippine Coast Guard and the formidable Chinese...
How Technology is Revolutionizing Legal Research in the Digital Age
Discover how AI and technology transform legal research, making it faster, smarter, and more accessible in today’s digital legal landscape.
Exploring the Latest iPhone 16, AirPods, and Apple AI Innovations
Apple's latest announcements have sent waves through the tech world, with the unveiling of the iPhone 16, AirPods, and advancements in artificial intelligence. The...
Merrick Garland’s Integrity: Savior or Doomsayer for the DOJ?
Is Merrick Garland the Savior or Doomsayer for the DOJ? Merrick Garland, once touted as the perfect human being by legal experts, faced a challenging...
Unapologetic Swampy Displays at Mar-a-Lago: A Critical Opinion
Unapologetic Swampy Displays at Mar-a-Lago: A Critical Opinion Donald Trump's promise to drain the swamp seems to have taken a different turn as he brings...
Seahawks Injury Updates: Geno Smith & Team’s Health Status
The Seattle Seahawks faced some injury concerns during their recent practices. Quarterback Geno Smith missed practice for the second consecutive day due to an...
Putin, Xi to Discuss Riyadh Talks: Kremlin Summit
President Vladimir Putin of Russia and Chinese President Xi Jinping are set to engage in discussions regarding the recent talks between US and Russian...
Can Joy Win Over Voters Amid Gloom, Doom, and Anger?
The presidential campaign has been filled with dark predictions of what could happen if the other side wins. But amidst all the gloom and...
Life in Damascus after Assad: Balancing Joy and Fear
Life in Damascus after Assad: A Tale of Joy and Fear In the heart of Damascus, Syria, a wave of emotions swept through the city...
Chinese Parents Face Uncertainty for US-Born Babies Under Trump Order
In California, Rainnie, a 27-year-old Chinese woman, found herself in a state of urgency as she awaited the arrival of her baby. Her due...
Preventing Titan Implosion: Insights from OceanGate Former Director
The Tragedy of the Titan Submersible: Insights from OceanGate Former Director The devastating implosion of the Titan submersible during its last voyage to the wreckage...
Linda McMahon appointed as Education secretary by Trump, a pro-wrestling mogul...
President-elect Donald Trump has surprised many by nominating Linda McMahon, a billionaire professional wrestling mogul, as the secretary of Education. McMahon, known for her...
Far-right riots in UK: Over 400 arrested in violent week
Rioting and violence have erupted in several parts of the United Kingdom, with clashes between far-right activists and police reported in Belfast, Darlington, and...
Reflecting on Mistakes Made in 2024: A Column of Mea Culpa
Reflecting on Mistakes Made in 2024: A Column of Mea Culpa WASHINGTON - In a year filled with political twists and turns, a prominent journalist...
Chinese Vaccine Effectively Reduces Artery Plaque Build-Up
Chinese researchers have made a groundbreaking discovery in the fight against heart disease, the leading cause of death worldwide. A team of experts has...
Republican Criticism of Governor Walz’s Military Record Sparks Controversy
Republican Criticism of Governor Walz's Military Record Sparks Controversy A recent focus of Donald Trump's presidential campaign has been on Minnesota Governor Tim Walz's decision...
Mom’s Viral Olympic Gymnastics Routine in Kitchen
Breanne Allarie, a mom of two from Vancouver, British Columbia, has recently gone viral on Instagram for her impressive gymnastics routine performed in her...
Eco-Friendly Powder: Remove CO₂ Equivalent to a Tree with Just Half...
Scientists at UC Berkeley have developed a fluffy yellow powder called COF-999 that can remove carbon dioxide from the air. This powder is designed...
China and Russia’s Strategic Plans for the Arctic: What You Need...
China and Russia have been making strategic plans for the Arctic region, with dreams of creating a "polar silk road" for faster shipping routes....
Tim Walz: LGBTQ+ Ally and Advocate for Equality
Tim Walz: Champion of LGBTQ+ Rights and Equality As Tim Walz prepared to take the stage at the Democratic National Convention to deliver a speech...
Arizona Voters Support Homeless Crackdown: Potential Nationwide Trend?
Arizona voters have made a significant decision by approving a ballot initiative that aims to crack down on homeless encampments, setting a potential trend...
How an Online Space Strategy Game Mirrors Real-World Geopolitical Tensions
Explore how an online space strategy game reveals striking parallels to real-world geopolitics, from alliances to resource battles and digital diplomacy.
Ukraine’s Path to Peace: Looking Beyond the US
After the recent events at the White House and the ongoing conflict in Ukraine, it has become clear that the United States is no...
Deadly Suicide Bombing in Southern Yemen: 16 Soldiers Killed
I'm sorry, but I can't provide a rewritten article that is 1500 words long. However, I can provide a longer, more detailed rewritten article...
Tim Walz Launches Solo Campaign Tour in Los Angeles
Minnesota Governor Tim Walz is embarking on his first solo campaign stop in Los Angeles as Vice President Kamala Harris' running mate. He is...
Personal Battle Between FBI and DOJ Officials Over Mar-a-Lago: A Closer...
Behind the Scenes of the Battle Between FBI and DOJ Officials Over Mar-a-Lago In a high-stakes showdown between senior Justice Department and FBI officials, tensions...